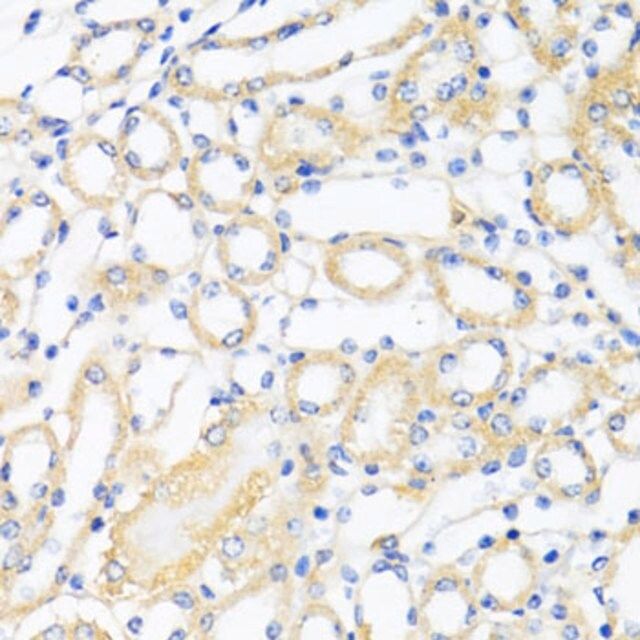

ن؛§ه“پهگچ称9ü/div>
Anti-CTGF antibody produced in rabbit
CTGF
HCS24
CCN2
IGFBP8
ن؛§ه“پن»‹ç»چï¼™ü/div>
ن؛§ه“پ说وکژ
ن¸€èˆ¬وڈڈè؟?/p>
The protein encoded by this gene is a mitogen that is secreted by vascular endothelial cells. The encoded protein plays a role in chondrocyte proliferation and differentiation, cell adhesion in many cell types, and is related to platelet-derived growth factor. Certain polymorphisms in this gene have been linked with a higher incidence of systemic sclerosis.
ه…چç–«هژü/p>
Recombinant fusion protein containing a sequence corresponding to amino acids 27-349 of human CTGF (NP_001892.1).
ه¤–ه½¢
PBS with 0.02% sodium azide,50% glycerol,pH7.3.
ه‚¨هکهڈٹ稳ه®ڑو€?/p>
Store at -20â„? Avoid freeze / thaw cycles.
ن؛§ه“پو€§è´¨
| ç”ں物و¥و؛گ |
rabbit |
| è´¨é‡ڈو°´ه¹³ |
100 |
| وٹ—ن½“ه½¢ه¼ڈ |
affinity isolated antibody |
| antibody product type |
primary antibodies |
| ه…‹éڑ† |
polyclonal |
| ه½¢ه¼ڈ |
buffered aqueous solution |
| هˆ†هگé‡ژü/td> |
35
38 |
| species reactivity |
mouse, human, rat |
| وµ“ه؛¦ |
3.97 mg/ml |
| technique(s) |
immunofluorescence: 1:20-1:50
immunohistochemistry: 1:50-1:200
western blot: 1:500-1:2000 |
| UniProt登记هڈ¶ü/td> |
P29279 |
| è؟گ输 |
wet ice |
| ه‚¨هکو¸©ه؛¦ |
?20â„‚ü/td> |
| Gene Information |
human ... CTGF(1490) |
ه®‰ه…¨ن؟،وپ¯
| ه‚¨هکهˆ†ç±»ن»£ç پ |
12 - Non Combustible Liquids |
| WGK |
WGK 1 |
| é—ھ点(F) |
Not applicable |
| é—ھ点(C) |
Not applicable |
 m.cnreagent.com
m.cnreagent.com